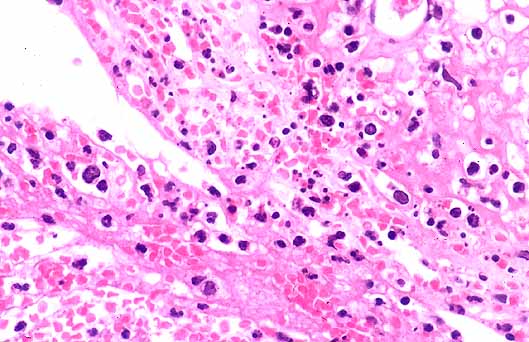
fig. 2
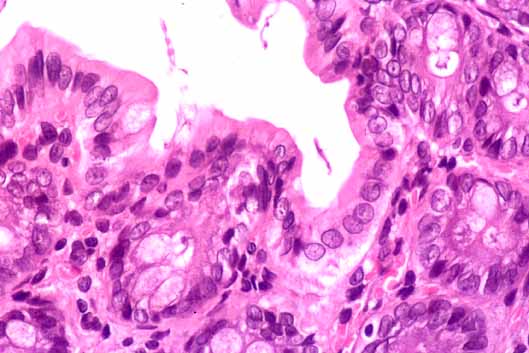
fig. 4

Comunicación
Nş 039
Comunicación |
Xavier Farré, Joan Rodó, Manel Solé, Eduardo Martín, Antonio Cardesa.
 |
| Figura 1.- Vejiga urinaria. Mucosa vesical ulcerada con fibrina en la superficie, edema subepitelial intenso en la pared, congestión y abundante material fibrino-hemorrágico. (x40) |
|
| Figura 2.- Vejiga urinaria. Mucosa ulcerada con abundantes polimorfonucleares y presencia de fibrina y hemorragia. (x200) |
 |
| Figura 3.- Colon. Mucosa colónica con glándulas y lámina propia de aspecto normal. Discreta congestión de la submucosa. Escaso material inflamatorio intraluminal. (x40) |
|
| Figura 4.- Colon. Mucosa colónica con abundantes células caliciformes en las glándulas. Lamina propia sin particularidades. (x200) |
 |
| Figura 5.- Colon. Fenómenos de apoptosis en las células de las criptas glandulares de la mucosa. (x100) |
 |
| Figura 6.- Zona de anastomosis. Proceso inflamatorio intenso con presencia de material de sutura y algunas células gigantes de tipo "cuerpo extrańo". (x40) |